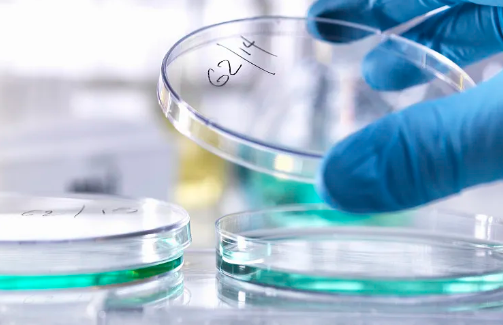
image.png

尿道干細(xì)胞修復(fù)費(fèi)用大概多少,修復(fù)原理和作用是什么
2024-09-18 14:50:04 來源: 小編 咨詢醫(yī)生
尿道干細(xì)胞修復(fù)費(fèi)用大概多少
尿道干細(xì)胞修復(fù)是一種相對(duì)新穎的醫(yī)學(xué)技術(shù),廣泛應(yīng)用于尿道損傷、尿失禁和其他相關(guān)泌尿系統(tǒng)疾病的治療。盡管具體費(fèi)用因地區(qū)、醫(yī)院及治療方案的不同而有所差異,一般來說,尿道干細(xì)胞修復(fù)的費(fèi)用主要包括以下幾個(gè)方面:
1.診斷費(fèi)用:在進(jìn)行干細(xì)胞修復(fù)前,需要進(jìn)行相關(guān)的檢查與診斷,包括影像學(xué)檢查、實(shí)驗(yàn)室檢查等。這部分費(fèi)用通常在500~2000元之間。
2.干細(xì)胞提取與培養(yǎng)費(fèi)用:干細(xì)胞的提取和培養(yǎng)是一項(xiàng)技術(shù)性強(qiáng)的操作,這部分費(fèi)用可能在1萬元到3萬元不等,具體金額取決于所選項(xiàng)目和技術(shù)平臺(tái)。
3.手術(shù)費(fèi)用:干細(xì)胞修復(fù)手術(shù)的費(fèi)用,包括手術(shù)室使用費(fèi)、麻醉費(fèi)及醫(yī)師操作費(fèi),通常在5000~2萬元之間。
4.術(shù)后隨訪及恢復(fù)治療費(fèi)用:術(shù)后需要進(jìn)行一定的隨訪和康復(fù)治療,這部分費(fèi)用可能每月需要1000~3000元。
綜上,尿道干細(xì)胞修復(fù)的總費(fèi)用大致在2萬元到6萬元之間,具體費(fèi)用還需根據(jù)患者的個(gè)體情況和醫(yī)院的收費(fèi)標(biāo)準(zhǔn)來定。
修復(fù)原理
尿道干細(xì)胞修復(fù)主要依賴于干細(xì)胞的自我更新和分化能力。干細(xì)胞是一類尚未成熟的細(xì)胞,具有分化為多種細(xì)胞類型的潛能。在尿道損傷或疾病的情況下,采用干細(xì)胞治療時(shí),通常會(huì)從患者自身或異體來源提取干細(xì)胞,然后將其培養(yǎng)并注入到受損尿道或相關(guān)組織中。
1.促進(jìn)組織再生:干細(xì)胞可以通過分化成尿道上皮細(xì)胞、平滑肌細(xì)胞等,促進(jìn)尿道組織的再生,恢復(fù)其結(jié)構(gòu)和功能。
2.抗炎作用:尿道損傷后,局部會(huì)出現(xiàn)炎癥反應(yīng)。干細(xì)胞具有調(diào)節(jié)免疫和抗炎的作用,可以降低局部炎癥,促進(jìn)愈合。
3.分泌生長因子:干細(xì)胞能分泌多種生長因子,進(jìn)一步促進(jìn)細(xì)胞增殖和組織修復(fù),提高尿道恢復(fù)的效率。
作用
尿道干細(xì)胞修復(fù)不僅限于尿道組織的結(jié)構(gòu)恢復(fù),還具有多重作用:
1.改善尿流功能:通過修復(fù)的組織恢復(fù)正常張力和彈性,能夠有效改善尿流功能,減輕尿失禁等癥狀。
2.提高生活質(zhì)量:尿道修復(fù)后,患者的生活質(zhì)量會(huì)顯著提高,包括減少疾病痛苦及改善心理狀態(tài)。
3.降低再發(fā)風(fēng)險(xiǎn):干細(xì)胞修復(fù)后的尿道組織更為健康,能夠有效地降低病變的再發(fā)風(fēng)險(xiǎn)。
4.促進(jìn)全面康復(fù):尿道的修復(fù)有利于整個(gè)泌尿系統(tǒng)功能的改善,能夠幫助患者更快地恢復(fù)正常生活。
尿道干細(xì)胞修復(fù)技術(shù)雖然具有諸多優(yōu)點(diǎn),但具體的適應(yīng)癥和效果因人而異,患者在選擇治療方案時(shí),建議與專業(yè)醫(yī)生充分溝通,了解各項(xiàng)細(xì)節(jié),以做出最佳決策。
文章來源:https://www.2008eshop.cn/ganxibao/37731.html
- 2024-08-23脂溢性脫發(fā)干細(xì)胞療法有效果嗎
- 2024-11-13干細(xì)胞治療白內(nèi)障效果好嗎,多少費(fèi)用一次
- 2024-10-28干細(xì)胞療法如何修復(fù)脊髓神經(jīng)?
- 2024-10-29臺(tái)州人體干細(xì)胞作用具體有哪些?治療哪些疾???
- 2024-11-10干細(xì)胞治療脊柱炎可以根治嗎,效果如何
- 2024-08-07干細(xì)胞療法治療肝硬化,干細(xì)胞治療肝硬化有效果嗎
- 2024-07-27存儲(chǔ)干細(xì)胞費(fèi)用,存儲(chǔ)干細(xì)胞的作用和功效
- 2024-07-31腫瘤干細(xì)胞治療,腫瘤干細(xì)胞治療機(jī)制是什么
- 2024-10-11干細(xì)胞移植后怎么看效果?如何評(píng)估治療效果?
- 2024-09-04干細(xì)胞除皺價(jià)格多少,和肉毒素除皺哪個(gè)效果好
- 2024-09-12干細(xì)胞十大公司排名,內(nèi)附收費(fèi)明細(xì)表
- 2024-09-11干細(xì)胞存儲(chǔ)機(jī)構(gòu)排名,干細(xì)胞十大公司排名及價(jià)格
- 2024-08-28甲狀腺結(jié)節(jié)用干細(xì)胞療法有用嗎多少錢
- 2024-07-17干細(xì)胞療法治療腦梗有效果嗎,干細(xì)胞治療腦梗最新進(jìn)展
- 2024-09-20打干細(xì)胞抗衰老有副作用嗎
- 2024-09-05我國干細(xì)胞制備技術(shù)發(fā)展現(xiàn)狀
- 2024-08-15造血干細(xì)胞的主要功能特點(diǎn)
- 2024-08-09干細(xì)胞療法治療腰突有希望嗎
